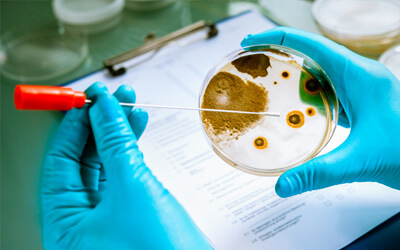

FAKOLITH Anti Schimmel Seminar
Einladung zum Praxisseminar
Bei Schimmel gibt es häufig unterschiedliche Auffassungen zum Schadensumfang und den Ursachen. Durch profunde Fachkenntnisse und professionelles Auftreten können Sie Reklamationen und Gewährleistungsansprüche vermeiden:
- Untergrundsanierung – Gesundheitsrisiken für Mitarbeiter minimieren
- der richtige Beschichtungsaufbau schützt vor erneutem Schimmelbefall
- rechtlich relevante Verordnungen
- Fallbeispiele aus der Praxis
Qualifizieren Sie sich für eine fachmännisch ausgeführte Schimmelsanierung mit den FAKOLITH-Systemprodukten.
Diese Seminar richtet sich an alle Verarbeiter, die sich im Umgang mit Schimmel Sachkenntnis aneignen wollen.
Es wird nach dem Seminar ein Teilnahmezertifikat ausgestellt.
Das Seminar kostet 78,00 euro pro Person zzgl MwSt.
Anwendungstechnik / Beratung
Sollten Sie in unserem Produktportfolio nicht das passende Produkt für Ihre Anforderungen finden, Fragen zu ausgewählten Produkten haben oder eine weiterführende Beratung wünschen, rufen Sie uns gern persönlich an oder schreiben Sie uns eine E-Mail.
Telefon: +49 (0)6253 / 23 94 – 18
Beratungszeiten: Montag bis Freitag 7.30 – 12.00 Uhr und 13.00 – 16.00 Uhr
E-Mail: anwendungstechnik@fakolith.de

